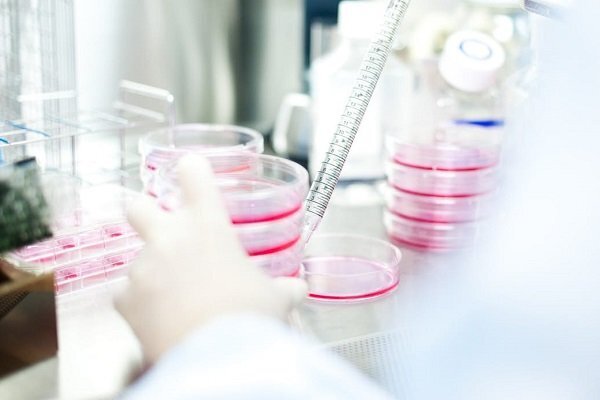

Stem cell council focused on cell therapy, gene therapy and tissue engineering
TEHRAN – The Council for Stem Cell Sciences and Technologies is focused on new technologies like cell therapy, gene therapy and tissue engineering, the council’s director Amir Ali Hamidieh announced, Mehr reported on Tuesday.
Supporting different organizations could accelerate manufacturing and marketing of knowledge-based stem cell products, he said.
The council, which is affiliated to the vice presidency for science and technology, seeks to support stem cell activities of knowledge-based companies, he added.
“Food and Drug Administration of Iran is one of the main organizations related to this field in Iran.”
The council plans to establish a strategic committee in the field of stem cell in order to support knowledge-based companies, he said.
According to the Royan Institute for stem cell biology and technology, Iran is one of the most pioneering countries in the world and the second country in the region in terms of stem cell knowledge and technology.
According to ncbi.com, stem cell technology is a rapidly developing field that combines the efforts of cell biologists, geneticists, and clinicians and offers hope of effective treatment for a variety of malignant and non-malignant diseases.
SB/MG
Leave a Comment